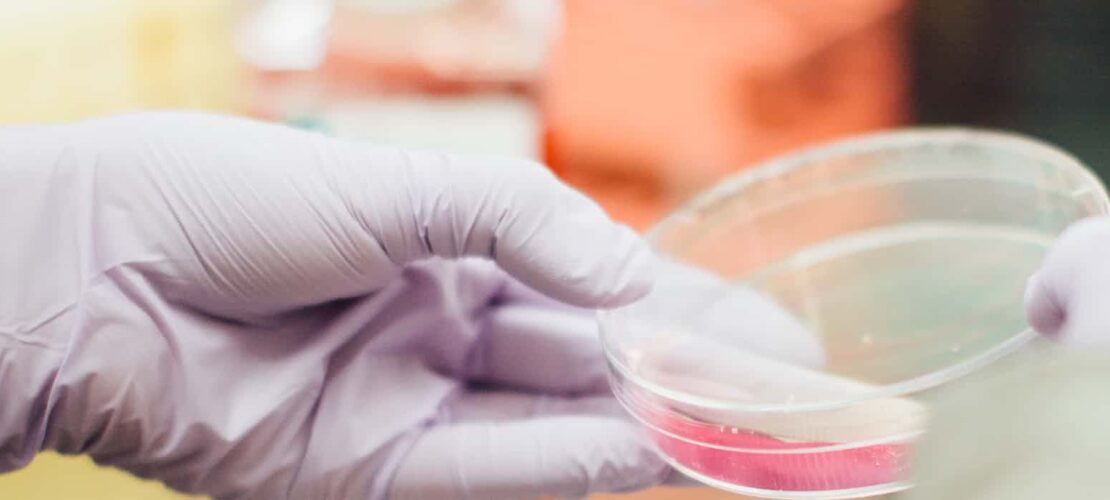
placeholder

1. Làm trắng răng là gì?
Làm trắng răng là quá trình loại bỏ các vết ố, xỉn màu và cải thiện màu sắc của răng, giúp răng trở nên sáng bóng và trắng hơn. Đây là một trong những phương pháp thẩm mỹ răng phổ biến, mang lại nụ cười tự tin và thu hút.
2. Các phương pháp làm trắng răng phổ biến
Hiện nay, có nhiều cách để làm trắng răng, bao gồm:
- Tại phòng khám nha khoa:
- Sử dụng công nghệ laser hoặc đèn LED kết hợp với thuốc tẩy trắng chuyên dụng.
- Phương pháp này mang lại hiệu quả cao và nhanh chóng.
- Tại nhà:
- Sử dụng máng tẩy trắng: Nha sĩ cung cấp máng đeo tùy chỉnh và thuốc tẩy trắng để sử dụng tại nhà.
- Dùng sản phẩm làm trắng: Kem đánh răng, miếng dán làm trắng hoặc gel bôi răng.
- Phương pháp tự nhiên:
- Súc miệng với dầu dừa: Loại bỏ vi khuẩn và giúp răng sáng hơn.
- Sử dụng baking soda: Trộn baking soda với nước hoặc kem đánh răng.
- Ăn trái cây: Dâu tây hoặc vỏ chuối được cho là có tác dụng làm trắng răng nhẹ nhàng.
3. Lưu ý khi làm trắng răng
- Tránh ăn uống các thực phẩm dễ gây ố răng (cà phê, trà, rượu vang đỏ) sau khi làm trắng.
- Không lạm dụng thuốc tẩy trắng, vì có thể gây mòn men răng.
- Phương pháp tự nhiên thường hiệu quả chậm, nhưng an toàn hơn so với hóa chất.
- Tham khảo ý kiến nha sĩ trước khi sử dụng bất kỳ sản phẩm làm trắng nào.
4. Những câu hỏi thường gặp
- Làm trắng răng có đau không?
Quá trình làm trắng răng tại phòng khám thường không đau. Tuy nhiên, một số người có thể cảm thấy ê buốt nhẹ sau khi tẩy trắng. - Hiệu quả làm trắng kéo dài bao lâu?
Thường từ 6 tháng đến vài năm, tùy thuộc vào chế độ ăn uống và vệ sinh răng miệng. - Ai không nên làm trắng răng?
Phụ nữ mang thai, trẻ em dưới 16 tuổi và người có răng nhạy cảm nên hạn chế hoặc tránh làm trắng răng.